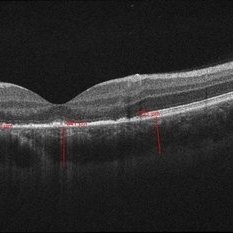
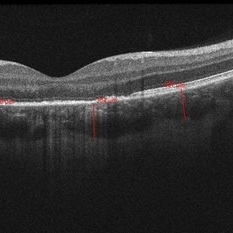
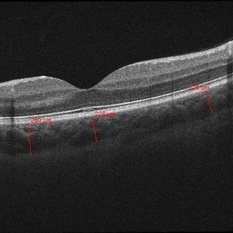

Search results (786 results)
-
 Slide 10-25
Slide 10-25
Feb 26 2019 by Lancaster Course in Ophthalmology
Phacolytic glaucoma. Histiocytes on the surface of the ciliary epithelium ( x 110). (Scheie Eye Institute, No. 3311.)
Condition/keywords: epithelium, phacolytic glaucoma
-
 Slide 12-16
Slide 12-16
Feb 27 2019 by Lancaster Course in Ophthalmology
lridoschisis. The large space present abnormally between the anterior and posterior iris stromal fibers. Note the lifting off of the corneal epithelium to form a bullous keratopathy (H&E x16).
Condition/keywords: epithelium, iridoschisis, keratopathy
-
 Slide 12-24
Slide 12-24
Feb 27 2019 by Lancaster Course in Ophthalmology
Sequelae. Basal layer of the corneal epithelium is pale and swollen by edema fluid. Further accumulation of edema fluid will lift the epithelium off of Bowman's membrane, resulting in bullous keratopathy (see Slide 12-16) (Masson's tri chromex250).
Condition/keywords: edema, epithelium, sequelae
-
Slide 2-28
Feb 19 2019 by Lancaster Course in Ophthalmology
Ciliary body showing clumps of pigment derived from necrotic ciliary pigment epithelium. Note the mild round cell infiltrate around vessels.
Condition/keywords: ciliary, epithelium, necrotic ciliary pigment
-
Slide 2-38
Feb 19 2019 by Lancaster Course in Ophthalmology
Marked atrophy of the iris stroma and pigment epithelium, virtual absence of stromal pigment, and scanty but diffuse round cell infiltrate in chronic nongranulomatous anterior uveitis.
Condition/keywords: atrophy, chronic nongranulomatous anterior uveitis, epithelium, iris, stroma
-
Slide 3-22
Feb 20 2019 by Lancaster Course in Ophthalmology
View of choroid in eye with sarcoid uveitis, lymphocytes, and epithelioid cells with extension to sclera and degenerative changes in retinal pigment epithelium ( x65) .
Condition/keywords: choroid, epithelioid cells, epithelium, lymphocytes, sarcoid, sclera
-
 Slide 5-19
Slide 5-19
Feb 20 2019 by Lancaster Course in Ophthalmology
Keratinizing epithelium lining a dermoid cyst in the center, with keratin contents and a single large hair above. The connective tissue wall has a large hair follicle in it.
Condition/keywords: cyst, epithelium
-
 Slide 5-24
Slide 5-24
Feb 20 2019 by Lancaster Course in Ophthalmology
Inverted follicular keratosis with thick, acanthotic, folded epithelium and keratin cysts.
Condition/keywords: acanthosis, cyst, epithelium
-
 Slide 5-3
Slide 5-3
Feb 20 2019 by Lancaster Course in Ophthalmology
Loss of orderly maturation of epidermal cells (dysplasia). The red blood cell-like ellipse in the center of the epithelium is a cell which has keratinized out of place (dyskeratosis).
Condition/keywords: dyskeratosis, dysplasia, epidermal cells, epithelium
-
 Slide 5-36
Slide 5-36
Feb 25 2019 by Lancaster Course in Ophthalmology
Basal cell carcinoma originating from five separate sites in the surface epithelium over the lacrimal punctum and canaliculus.
Condition/keywords: basal cell, canaliculus, epithelium, lacrimal punctum
-
 Slide 5-37
Slide 5-37
Feb 25 2019 by Lancaster Course in Ophthalmology
Edge of squamous cell carcinoma of the skin showing sudden change from normal epithelium to infiltrating islands of large, malignant squamous cells.
Condition/keywords: epithelium, squamous cells
-
 Slide 5-9
Slide 5-9
Feb 20 2019 by Lancaster Course in Ophthalmology
Verruca vulgaris of the lid showing acanthotic downgrowths of epithelium incurving toward the center.
Condition/keywords: acanthosis, epithelium, verruca vulgaris
-
 Slide 7-102
Slide 7-102
Feb 25 2019 by Lancaster Course in Ophthalmology
Epithelial downgrowth. The epithelium has grown onto the posterior surface of the iris.
Condition/keywords: epithelial, epithelium, iris
-
 Slide 7-26
Slide 7-26
Feb 25 2019 by Lancaster Course in Ophthalmology
Acquired melanosis of the conjunctiva showing hyperpigmentation of the basal layer of the epithelium.
Condition/keywords: conjunctiva, epithelium, melanosis
-
 Slide 7-36
Slide 7-36
Feb 25 2019 by Lancaster Course in Ophthalmology
Herpes simplex keratitis is characterized by irregularity of the epithelium, patchy loss of Bowman's membrane, infiltration by lymphocytes and plasma cells, and vascularization of the stroma.
Condition/keywords: Bowman's membrane, epithelium, Herpes, lymphocytes, plasma cells, stroma
-
 Slide 7-43
Slide 7-43
Feb 25 2019 by Lancaster Course in Ophthalmology
Granular dystrophy showing clumps of hyaline degeneration beneath the epithelium and in the stroma which stain red with Masson trichrome stain in comparison to the normal blue background.
Condition/keywords: epithelium, granular corneal dystrophy, hyaline degeneration, stroma
-
 Slide 7-83
Slide 7-83
Feb 25 2019 by Lancaster Course in Ophthalmology
Traumatic retinopathy showing loss of retinal architecture, patchy disruption of the retinal pigment epithelium, and migration of pigment into the atrophic retina.
Condition/keywords: epithelium, retinopathy
-
 "Mud-Splatter" of Posterior Pole and Peripheral Radial Streaks in a Carrier of Ocular Albinism
"Mud-Splatter" of Posterior Pole and Peripheral Radial Streaks in a Carrier of Ocular Albinism
Jan 22 2019 by John S. King, MD
14-year-old healthy white female with family history of ocular albinism was seen by Dr. Hruby for a second opinion. Father and some of his brothers were positive for a history of ocular albinism. Va cc 20/30 J1+ OU; no nystagmus; no TIDs; no foveal hypoplasia. A "mud-spatter" appearance to the posterior pole was present, along with peripheral alternating streaks. Hypoautofluorescent areas correspond to hyperpigmented areas of retinal pigment epithelium, and vice versa (see photo). Dr. Hruby agreed that this was most likely a carrier of Ocular Albinism Type-1 (XR; GPR143 mutation), and possible genetic testing/counselling was discussed.
Photographer: Gretchen Harper
Imaging device: Optos California
Condition/keywords: Nettleship-Falls ocular albinism, ocular albinism
-
 01 Unilateral Acute Idiopathic Maculopathy (UAIM) Pseudocolor Photograph OD
01 Unilateral Acute Idiopathic Maculopathy (UAIM) Pseudocolor Photograph OD
Jul 24 2018 by Hosam Attia, MD
20-year-old white, male presented for initial evaluation with one week history of acute, sudden, painless loss of central vision in his right eye a week prior to presentation. - H/O short course of exogenous testosterone, Tamoxifen and Clomiphene intake ~ 2-3 weeks cycle, which was already stopped, prior to development of pt's symptoms. - H/O acute illness with generalized fatigue, malaise, URTI like symptoms and rash over the hands and chest, just prior to symptoms development, and upon further discussion, patient mentioned that few of his friends got sick around the same time. - Patient was seen the week prior by general ophthalmologist and was found to have SRF on OCT , diagnosed with CSCR and referred for retina evaluation. - ROS/ PMHx: negative, healthy aside from the short illness described above - Denied any prior vision problems, similar episodes, trauma etc - VA Dsc OD: 20/400 OS:20/20 - anterior segment exam - unremarkable - posterior segment - macular RPE changes/ clumping with GA with no CME/ SRF or crystals OD, and unremarkable OS. - pseudocolor and FAF photos: RPE changes/ clumps with GA and stippled autofluorescense OD, unremarkable OS. - HD SD-OCT: thickened choroid, thickened/ hypertrophied subfoveal RPE with hyper-reflective material on the apical side of the retinal pigment epithelium/apical debris, subfoveal ellipsoid zone atrophy with intact ELM with no CME or SRF OD, unremarkable OS. - FA: Dye not available - ICG: deferred - mf-ERG and VF - patient rescheduled
Imaging device: Optos - California
Condition/keywords: unilateral acute idiopathic maculopathy
-
 02 Unilateral Acute Idiopathic Maculopathy (UAIM) - Pseudocolor Photograph OS
02 Unilateral Acute Idiopathic Maculopathy (UAIM) - Pseudocolor Photograph OS
Jul 24 2018 by Hosam Attia, MD
20-year-old white, male presented for initial evaluation with one week history of acute, sudden, painless loss of central vision in his right eye a week prior to presentation. - H/O short course of exogenous testosterone, Tamoxifen and Clomiphene intake ~ 2-3 weeks cycle, which was already stopped, prior to development of pt's symptoms. - H/O acute illness with generalized fatigue, malaise, URTI like symptoms and rash over the hands and chest, just prior to symptoms development, and upon further discussion, pt mentioned that few of his friends got sick around the same time. - Patient was seen the week prior by general ophthalmologist and was found to have SRF on OCT , diagnosed with CSCR and referred for retina evaluation. - ROS/ PMHx: Negative, healthy aside from the short illness described above - Denied any prior vision problems, similar episodes, trauma etc - VA Dsc OD: 20/400 OS:20/20 - anterior segment exam - unremarkable - posterior segment - macular RPE changes/ clumping with GA with no CME/ SRF or crystals OD, and unremarkable OS. - Pseudocolor and FAF photos: RPE changes/ clumps w/ GA and stippled autofluorescense OD, unremarkable OS. - HD SD-OCT: thickened choroid, thickened/ hypertrophied subfoveal RPE with hyper-reflective material on the apical side of the retinal pigment epithelium/apical debris, Subfoveal ellipsoid zone atrophy w/ intact ELM W/No CME or SRF OD, Unremarkable OS. - FA: Dye not available - ICG: deferred - mf-ERG & VF - patient rescheduled
Imaging device: Optos - California
Condition/keywords: unilateral acute idiopathic maculopathy
-
 03- Unilateral Acute Idiopathic Maculopathy (UAIM) - FAF OD
03- Unilateral Acute Idiopathic Maculopathy (UAIM) - FAF OD
Jul 24 2018 by Hosam Attia, MD
20-year-old white, male presented for initial evaluation with one week history of acute, sudden, painless loss of central vision in his right eye a week prior to presentation. - H/O short course of exogenous testosterone, Tamoxifen and Clomiphene intake ~ 2-3 weeks cycle, which was already stopped, prior to development of patient's symptoms. - H/O acute illness with generalized fatigue, malaise, URTI like symptoms and rash over the hands and chest, just prior to symptoms development, and upon further discussion, pt mentioned that few of his friends got sick around the same time. - Patient was seen the week prior by general ophthalmologist and was found to have SRF on OCT , diagnosed w/ CSCR and referred for retina evaluation. - ROS/ PMHx: Negative, healthy aside from the short illness described above - Denied any prior vision problems, similar episodes, trauma etc - VA Dsc OD: 20/400 OS:20/20 - anterior segment exam - unremarkable - posterior segment - macular RPE changes/ clumping with GA with no CME/ SRF or crystals OD, and unremarkable OS. - Pseudocolor & FAF photos: RPE changes/ clumps with GA and stippled autofluorescense OD, Unremarkable OS. - HD SD-OCT: thickened choroid, thickened/ hypertrophied subfoveal RPE with hyper-reflective material on the apical side of the retinal pigment epithelium/apical debris, subfoveal ellipsoid zone atrophy with intact ELM with no CME or SRF OD, unremarkable OS. - FA: Dye not available - ICG: deferred - mf-ERG & VF - pt rescheduled!
Imaging device: Optos - California
Condition/keywords: unilateral acute idiopathic maculopathy
-
 04- Unilateral Acute Idiopathic Maculopathy (UAIM) - FAF OS
04- Unilateral Acute Idiopathic Maculopathy (UAIM) - FAF OS
Jul 24 2018 by Hosam Attia, MD
20-year-old white, male presented for initial evaluation with one week history of acute, sudden, painless loss of central vision in his right eye a week prior to presentation. - H/O short course of exogenous testosterone, Tamoxifen and Clomiphene intake ~ 2-3 weeks cycle, which was already stopped, prior to development of pateint's symptoms. - H/O acute illness with generalized fatigue, malaise, URTI like symptoms and rash over the hands and chest, just prior to symptoms development, and upon further discussion, patient mentioned that few of his friends got sick around the same time. - Patient was seen the week prior by general ophthalmologist and was found to have SRF on OCT, diagnosed with CSCR and referred for retina evaluation. - ROS/ PMHx: negative, healthy aside from the short illness described above - Denied any prior vision problems, similar episodes, trauma etc - VA Dsc OD: 20/400 OS:20/20 - anterior segment exam - unremarkable - posterior segment - macular RPE changes/ clumping with GA with no CME/ SRF or crystals OD, and unremarkable OS. - pseudocolor and FAF photos: RPE changes/ clumps with GA & stippled autofluorescence OD, unremarkable OS. - HD SD-OCT: thickened choroid, thickened/ hypertrophied subfoveal RPE with hyper-reflective material on the apical side of the retinal pigment epithelium/apical debris, subfoveal ellipsoid zone atrophy with intact ELM with no CME or SRF OD, unremarkable OS. - FA: Dye not available - ICG: deferred - mf-ERG & VF - patient rescheduled
Imaging device: Optos - California
Condition/keywords: unilateral acute idiopathic maculopathy
-
05- Unilateral Acute Idiopathic Maculopathy (UAIM) - OCT OD
05- Unilateral Acute Idiopathic Maculopathy (UAIM) - OCT OD
Jul 24 2018 by Hosam Attia, MD
20-year-old white, male presented for initial evaluation with one week history of acute, sudden, painless loss of central vision in his right eye a week prior to presentation. - H/O short course of exogenous testosterone, Tamoxifen and Clomiphene intake ~ 2-3 weeks cycle, which was already stopped, prior to development of pt's symptoms. - H/O acute illness with generalized fatigue, malaise, URTI like symptoms and rash over the hands and chest, just prior to symptoms development, and upon further discussion, pt mentioned that few of his friends got sick around the same time. - Patient was seen the week prior by general ophthalmologist and was found to have SRF on OCT , diagnosed with CSCR and referred for retina evaluation. - ROS/ PMHx: Negative, healthy aside from the short illness described above - Denied any prior vision problems, similar episodes, trauma etc - VA Dsc OD: 20/400 OS:20/20 - anterior segment exam - unremarkable - posterior segment - macular RPE changes/ clumping with GA with no CME/ SRF or crystals OD, and unremarkable OS. - Pseudocolor and FAF photos: RPE changes/ clumps w/ GA and stippled autofluorescense OD, unremarkable OS. - HD SD-OCT: thickened choroid, thickened/ hypertrophied subfoveal RPE with hyper-reflective material on the apical side of the retinal pigment epithelium/apical debris, Subfoveal ellipsoid zone atrophy w/ intact ELM W/No CME or SRF OD, Unremarkable OS. - FA: Dye not available - ICG: deferred - mf-ERG & VF - patient rescheduled
Imaging device: Zeiss-Cirrus 4000
Condition/keywords: unilateral acute idiopathic maculopathy
-
05- Unilateral Acute Idiopathic Maculopathy (UAIM) - OCT OD2
05- Unilateral Acute Idiopathic Maculopathy (UAIM) - OCT OD2
Jul 24 2018 by Hosam Attia, MD
20-year-old white, male presented for initial evaluation with one week history of acute, sudden, painless loss of central vision in his right eye a week prior to presentation. - H/O short course of exogenous testosterone, Tamoxifen and Clomiphene intake ~ 2-3 weeks cycle, which was already stopped, prior to development of pt's symptoms. - H/O acute illness with generalized fatigue, malaise, URTI like symptoms and rash over the hands and chest, just prior to symptoms development, and upon further discussion, pt mentioned that few of his friends got sick around the same time. - Patient was seen the week prior by general ophthalmologist and was found to have SRF on OCT , diagnosed with CSCR and referred for retina evaluation. - ROS/ PMHx: Negative, healthy aside from the short illness described above - Denied any prior vision problems, similar episodes, trauma etc - VA Dsc OD: 20/400 OS:20/20 - anterior segment exam - unremarkable - posterior segment - macular RPE changes/ clumping with GA with no CME/ SRF or crystals OD, and unremarkable OS. - Pseudocolor and FAF photos: RPE changes/ clumps w/ GA and stippled autofluorescense OD, unremarkable OS. - HD SD-OCT: thickened choroid, thickened/ hypertrophied subfoveal RPE with hyper-reflective material on the apical side of the retinal pigment epithelium/apical debris, Subfoveal ellipsoid zone atrophy w/ intact ELM W/No CME or SRF OD, Unremarkable OS. - FA: Dye not available - ICG: deferred - mf-ERG & VF - patient rescheduled
Imaging device: Zeiss-Cirrus 4000
Condition/keywords: unilateral acute idiopathic maculopathy
-
06- Unilateral Acute Idiopathic Maculopathy (UAIM) - OCT OS
06- Unilateral Acute Idiopathic Maculopathy (UAIM) - OCT OS
Jul 24 2018 by Hosam Attia, MD
20-year-old white, male presented for initial evaluation with one week history of acute, sudden, painless loss of central vision in his right eye a week prior to presentation. - H/O short course of exogenous testosterone, Tamoxifen and Clomiphene intake ~ 2-3 weeks cycle, which was already stopped, prior to development of pt's symptoms. - H/O acute illness with generalized fatigue, malaise, URTI like symptoms and rash over the hands and chest, just prior to symptoms development, and upon further discussion, pt mentioned that few of his friends got sick around the same time. - Patient was seen the week prior by general ophthalmologist and was found to have SRF on OCT , diagnosed with CSCR and referred for retina evaluation. - ROS/ PMHx: Negative, healthy aside from the short illness described above - Denied any prior vision problems, similar episodes, trauma etc - VA Dsc OD: 20/400 OS:20/20 - anterior segment exam - unremarkable - posterior segment - macular RPE changes/ clumping with GA with no CME/ SRF or crystals OD, and unremarkable OS. - Pseudocolor and FAF photos: RPE changes/ clumps w/ GA and stippled autofluorescense OD, unremarkable OS. - HD SD-OCT: thickened choroid, thickened/ hypertrophied subfoveal RPE with hyper-reflective material on the apical side of the retinal pigment epithelium/apical debris, Subfoveal ellipsoid zone atrophy w/ intact ELM W/No CME or SRF OD, Unremarkable OS. - FA: Dye not available - ICG: deferred - mf-ERG & VF - patient rescheduled
Imaging device: Zeiss-Cirrus 4000
Condition/keywords: unilateral acute idiopathic maculopathy

 Loading…
Loading…